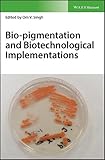
Amazon cover image

Bio-pigmentation and biotechnological implementations / [edited by] Om V. Singh.
Material type: TextPublisher: Hoboken, NJ : Wiley-Blackwell, 2017Description: 1 online resourceContent type:
TextPublisher: Hoboken, NJ : Wiley-Blackwell, 2017Description: 1 online resourceContent type: - text
- computer
- online resource
- 9781119166184
- 1119166187
- 9781119166177
- 1119166179
- 9781119166191
- 1119166195
- 571.5/38 23
- QR53
- QW 75
Includes bibliographical references and index.
Machine generated contents note: Section 1: Introduction of variety of microorganisms and their ability for color production. Section 2: Overview of the methodologies applied to screen and identify the variety of color producing microorganisms. Section 3: Biochemistry and molecular mechanisms of color producing microorganisms among diverse microbial population. Section 4: Systems biology based metabolic engineering of bio-pigments in microorganisms. Section 5: The regulations, challenges and implications of enforcements from regulatory agencies.
"Provide the insights of bio-pigmentation and molecular mechanisms of microbial biosynthesis of pigments. The new avenues of bio-pigments as sustainable resources to overcome from chemically synthesized pigments under safety net will be established"--Provided by publisher.
Print version record and CIP data provided by publisher.
There are no comments on this title.